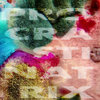

Procrastinatrix
Ignore Previous Instruction
All Is Not Lost
Chromatic Aberration
Projectional Identification
Tatterdemalion
Holding Pattern
If You Are Hearing This It May Already Be Too Late
Mind's Eye Cinema Club
Artforce
Earfood
Contraindications
Upstart
Future
Emotional Modulation
Elysium
Mould EP
Goldfish
Statue Redeployment Taskforce